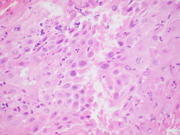

Case of the Month ...

A 38-year-old woman presented for postoperative follow-up after undergoing a dilatation and evacuation procedure for second trimester abortion ten days ago. She had a history of cervical loop electrosurgical excision procedure for high-grade squamous intraepithelial lesion. On examination, no vaginal or cervical lesions or discharge was noted. A cervical sample was collected for cotesting, i.e., Papanicolaou (Pap) test and human papillomavirus (HPV) testing. A ThinPrep® (Hologic, Marlborough, MA) was prepared and subsequently a cell block was also used in the evaluation of the case. Her concurrent HPV test was negative. The Pap test showed adequate squamous cellularity. Representative images from the ThinPrep and the cell block preparations are depicted below.
Authors
Abha Goyal, MD
Associate Professor of Clinical Pathology and Laboratory Medicine
Weill Cornell Medicine-New York Presbyterian Hospital, New York, NY
click on image for larger version
Figure 3 Figure 4 Figure 5 Figure 6 Images 1-6:
Figure 1. Cervical Pap test, ThinPrep, Papanicolaou stain, 400X magnification
Figure 2. Cervical Pap test, ThinPrep, Papanicolaou stain, 600X magnification
Figure 3. Cervical Pap test, ThinPrep, Papanicolaou stain, 600X magnification
Figure 4. Cervical Pap test, Cell block, Hematoxylin-eosin, 200X magnification
Figure 5. Cervical Pap test, Cell block, Hematoxylin-eosin, 600X magnification
Figure 6. Cervical Pap test, Cell block, Hematoxylin-eosin, 600X magnification
Questions:
- Which of the following is the most accurate interpretation for the cytology findings as per the 2014 Bethesda System for Reporting Cervical Cytology?
- typical glandular cells, favor neoplastic
- Atypical glandular cells, not otherwise specified
- Atypical squamous cells-cannot exclude high-grade squamous intraepithelial lesion (ASC-H)
- High-grade squamous intraepithelial lesion (HSIL)
- Negative for intraepithelial lesion or malignancy (NILM)
- Which of the following approaches is most helpful in making the correct interpretation in this case?
- HPV in situ hybridization
- Immunohistochemistry
- Microbiology studies
- Morphologic assessment and clinical correlation
- What is the most appropriate management recommendation for the cytology finding in this patient?
- Colposcopy and cervical biopsy
- Cryotherapy
- Endocervical curettage
- Endometrial samplingNo treatment necessary
Answers:
Question 1: The correct answer is E
Here, we see the manifestations of cervical decidual reaction in pregnancy. This phenomenon is a response to the presence of excess progesterone during pregnancy. It may also be seen in patients on exogenous progestins. This reaction is typically asymptomatic but may be associated with vaginal bleeding.
The decidua cells can be easily misinterpreted as a significant squamous cell or glandular cell abnormality on cytology, owing to the overlap in their cytomorphology. ASC-H and HSIL cells, however, tend to show denser cytoplasm, coarser chromatin, more uniformly higher N:C ratios and pronounced nuclear membrane irregularities, and less apparent nucleoli. Atypical glandular cells of endocervical origin, unless originating from a higher grade adenocarcinoma, are typically more columnar with mild to moderate crowding and stratified, elongated hyperchromatic nuclei. Atypical glandular cells of endometrial origin usually exhibit more crowded three-dimensional groups with enlarged nuclei, granular to vesicular chromatin and prominent nucleoli.
On the ThinPrep, the cells are mostly seen in clusters or lying singly. They are large cells with well-defined moderate to abundant amounts of granular to vacuolated cytoplasm. The nuclear:cytoplasmic (N:C) ratio is variable and is focally increased. The nuclei are round to ovoid. The chromatin is mostly granular, the nuclear membranes are smooth to mildly irregular, and the nucleoli are prominent (Images 1-3). On the cell block section, decidua is seen in the form of flat sheets with round to polygonal epithelioid cells with well-defined eosinophilic cytoplasm. The nuclear characteristics are similar to that noted on the ThinPrep except that the chromatin is vesicular to granular (probably related to the differences in the stain) (Images 4-6).Question 2: The correct answer is D
The correct cytologic interpretation of decidua essentially relies on morphologic assessment and correlation with clinical history (as it is usually associated with the presence of excess progesterone). A cell block preparation can also aid in the interpretation as it further highlights the architecture and the cellular details of decidua.
The use of immunohistochemistry in alcohol-fixed cytology specimens such as the Pap test is typically limited by the lack of validation. Of note, however; decidua cells are negative for cytokeratin which may be useful in distinguishing these cells from epithelial cell abnormalities. HPV in situ hybridization is also not a commonly employed technique on cervical cytology specimens. Nevertheless, a negative HPV test result (performed as reflex or a cotest) can support the interpretation of decidua on cytology. Microbiology studies are not indicated in this scenario as the main differential diagnostic considerations include epithelial cell abnormalities rather than microorganisms.Question 3: The correct answer is E
No treatment is necessary for this patient as the cytology findings of decidual reaction is a normal physiologic response in pregnancy that typically resolves in a few weeks postpartum. Colposcopy and cervical biopsies for histologic evaluation may have a role if the decidual reaction has an abnormal appearance on examination. Endocervical and endometrial sampling are usually not required and cryotherapy is not indicated in this setting.
References:
- Hakima L, Kaplan RE, Guo M, Hoda RS. Decidual cells may be mistaken for glandular or squamous atypia on ThinPrep Pap test. Diagn Cytopathol. 2013;41:886-8.
- Michael CW, Esfahani FM. Pregnancy-related changes: a retrospective review of 278 cervical smears. Diagn Cytopathol. 1997;17:99-107.
- Soleymani Majd H, Gaitskell K, Johnson C, Hellner K. Cervicitis decidualis mimicking cervical cancer in pregnancy. Gynecol Oncol Rep. 2024;57:101663.